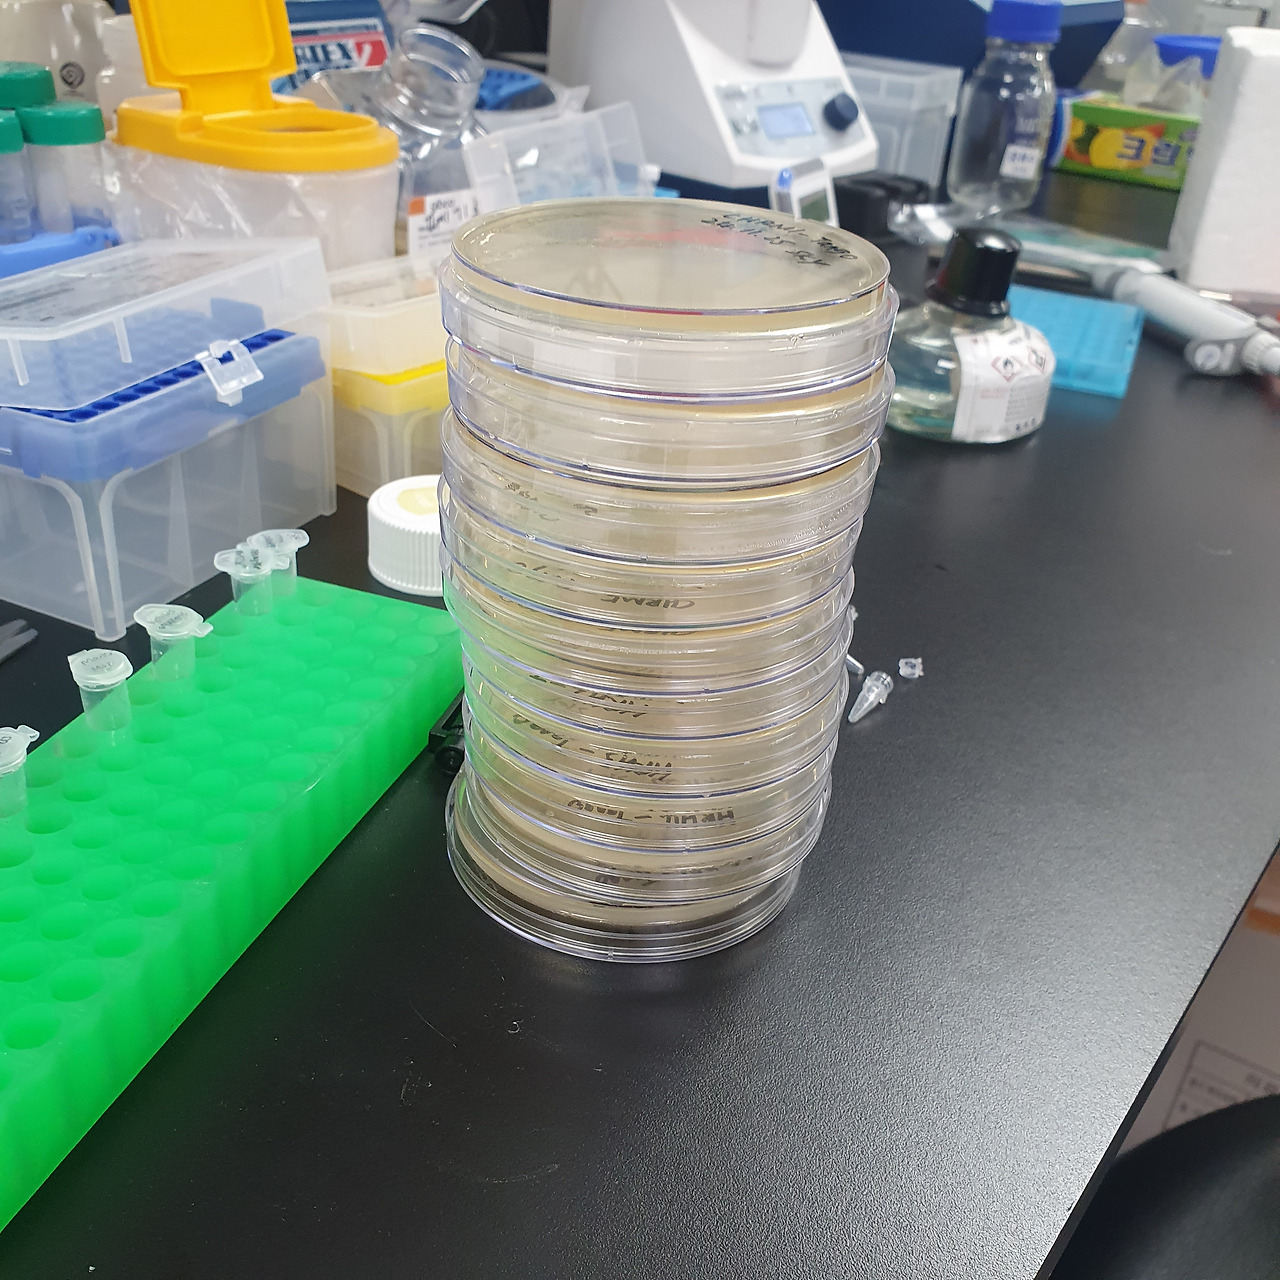
20241125_175421.jpg

생명공학도로 2막을 시작합니다.
의생명과학 연구원으로서의 발돋움
몇년간의 개발자로서 사업 진행하던 것을 마침표를 찍고, LLM의 등장과 함께 개발자의 포지셔닝에 대해 고민을 하던 중 젠슨황의 이야기에 동감이 되어 나는 15년 전 학부 때의 전공이었던 생명과학쪽으로 커리어 전환을 결정했다.
 "예전에는 컴퓨터공학을 전공하고 프로그래밍하는 법을 배워야 한다고 말했을 겁니다"
"예전에는 컴퓨터공학을 전공하고 프로그래밍하는 법을 배워야 한다고 말했을 겁니다" "만약 처음부터 다시 시작한다면 생물학을 했을 것이고 이것을 자녀에게 가르칠 것입니다"
"만약 처음부터 다시 시작한다면 생물학을 했을 것이고 이것을 자녀에게 가르칠 것입니다"그렇다해서 단순히 젠슨황의 말에 홀라당 넘어간건 아니고, 노화/비만치료 같은 분야가 가속화 되는 것에 관심을 갖게 되면서 학부(생명과학과 컴퓨터공학을 복수전공 하였음) 때 전공한 생명과학에 갑자기 관심을 가지게 된 것이다. 사실 나는 학부 때는 생명과학이 정말이지, 재미없었다. 외워야할 것은 왜 그렇게 많으며 그 작은 마이크로한 세상에서 일어나는 기작은 뭐가 그리 많은지...그 때는 인간 세상에 나와서 창업하고 외교하고 네트워킹하는 '큰 일' 들에 관심이 많았다. 그래서 생명과학은 버리고 컴퓨터공학을 택해서 석사까지 하고 개발자로서 지금까지 살아왔는데, LLM이 나타나면서 조금씩 의구심이 들기 시작했다.
웬만한 간단한 코드는 AI가 알아서 척척 짜주기도 하고 모르는게 있으면 바로 알려주고, 아주 편리한 세상이 도래한 것이다. 하지만 개발자 입장에서 이게 반길일이 맞나 싶은 것이다. 주니어급은 이제 필요가 없게 된게 아닐까 생각이 들었다. 그리고 좀 더 깊이 있게 공부해서 제대로 개발이나 엔지니어링을 아는 사람이 아니면 살아남기 어려운 분야가 되어간다는 것을 몸소 느끼게 된 것이다.
 cursor AI 활용 모습
cursor AI 활용 모습그리하여 앞으로 내 중년의 삶을 어떻게 살아갈지 고민하던 중, 중대한 결정을 내리게 되었다. 개발자의 삶이 아닌 생명공학자로서 살아가는 길을 택한 것이다. 마침 젠슨황 형님도 말씀해주셨고.내 주식수익율을 책임져주시는 고마운분
넉달 전 여름, BRIC 공고에서 재밌어 보이는 실험실 한 곳을 찾았다. 합성신경생물학 및 광유전학을 하는 곳이 었는데, 마치 생물학으로 프로그래밍을 하는 것과 같은 느낌이랄까. 구조체 조합을 통해 빛으로 단백질 유전자 발현을 조절하는 분야였는데 수동적이라고만 생각했던 분야가 능동적인 개입으로 조절이 가능하다는 점이 매우 매력적으로 다가왔다. 메일을 통해 교수님께 지원을 하고 그렇게 연구실에 연구원으로 들어가게 되었다.
연구실 생활은 녹록치 않았다. 15년만에 배우는 생명과학이란.. 모르는 것 투성이 였고, 제대로 오랜만에 잡아보는 파이펫은 낯설기 그지 없었다. 플라스미드가 뭔지도 기억나지 않는 나는 하나부터 열가지 다시 다 공부하며 몸으로 뛰고 머리를 굴리며 밤낮으로 배우고 진행했다. 특히 농도계산 같은건 오랜만에 하니까 왜이렇게 헷갈리는지 그 쉬운 계산이 잘 안되서 애를 참 많이 먹었다.
더군다나 실험실 생활도 적응해야 했지만 11월 말에 있는 대학원 입학시험도 준비해야했다.필기, 구술 시험이 있는데 필기시험에서 당락이 결정된다고 했다. 필기시험은 직무적합성 검사같은 것이라 하고, 범위는 없고 재수생을 배출하기도 하는 난이도의 시험이라는 소문이 퍼져있었다. 사실 기출문제도 있었지만 매번 새로운 문제를 내기에 별로 소용없기도 해서 사실상 어디서 문제가 나올지 모르는 것이기도 했다.
나는 실험이 저녁8시쯤 끝나면 매번 도서관으로 달려가 대학 4년 일반생물학,분자생물학,세포생물학 인강,교과서를 펴보며 공부를 했다. 옛날에 공부한 것들이라 마냥 새롭지만은 않았지만 외울 것이 방대했기에 머리가 터지는 줄 알았다. 몇달간은 주말도없이 숨도 안쉬고 공부만 했던 것 같다. 그리고 지난주 토요일 대학원 입학 필기,구술 시험을 치르고 이제서야 수험생 삶에서 벗어났다.

시험이 끝났으니 한숨을 돌리려던 찰나, 본격적인 프로젝트가 시작되며 실험 강도가 높아졌다. 실험을 동시에 세네개를 돌리며 앉아있을 새 없이 실험을 진행했다. 그래도 느리지만 조금씩 성장하고 배워가는 중이다. 현재까지는 클로닝 실험과 cell culture 및 발현 실험을 위주로 하고 있다. 앞으로는 공장 돌리듯이 할테니 익숙해질거라 생각한다.
인더스트리에 오래있다보면 공부가 하고싶어지나보다. 아무리 힘들어도 공부가 참 재밌다. 내 나이면 이제 졸업하고 교수가 될 나인데, 나는 이제서야 박사를 시작하니 한편으로는 민망하기도 하다만, 나는 또다른 나만의 길이 있을 것이라 생각하고 전진해야겠다.
나는 왜 이 길에 서 있나~ 이게 정말 나의 길인가~이 길의 끝에서 난 웃을 수 있을까~
-god '길'-